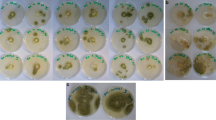

Abstract
In the present study, after molecular identification of dominant lactic acid bacteria (LAB) isolated from traditional fermented foods, antifungal activity of the isolates was investigated against aflatoxigenic Aspergillus spp. Based on screening results, among the isolated LAB, Pediococus lolii had the highest inhibitory effect against Aspergillus flavus (70.32%) and Aspergillus niger (98.8%). Furthermore, antifungal activity of P. lolii stationary phase cell-free supernatant (CFS) was significantly (P < 0.05) higher than the effect of the logarithmic phase CFS. MIC values of P. lolii CFSs from logarithmic and stationary phases against A. flavus were 2 and 1%, and against A. niger were 4 and 1% (v/v), respectively. The media containing ≥4% of CFSs from logarithmic and stationary phases (v/v) had also totally inhibited from germination of A. flavus and A. niger spores. Safety assessment during 28-day oral administration of P. lolii revealed that there was no noticeable difference in specific growth rate, activity, behavior, hair luster, clinical chemistry, and hematological indices in treated rats in comparison to control group.
Similar content being viewed by others
Avoid common mistakes on your manuscript.
Introduction
Almost all animal feeds are potentially susceptible to toxigenic molds at any stage during storage, processing, packaging, and transportation. These types of molds produce mycotoxins that are highly toxic secondary metabolites (Rather et al. 2014; Quiles et al. 2016). Aflatoxins are one of the six major classes of mycotoxins produced mainly by Aspergillus species such as Aspergillus flavus and Aspergillus niger (Khanafari et al. 2007). Aflatoxin B1 (AFB1) is the most potent teratogenic, cancerogenic, and oestrogenic agent and a major risk factor for liver cancer (Kabak et al. 2009).
Consumption of contaminated feeds with aflatoxigenic Aspergillus spp. could have serious problem to public health. Therefore, effort to reduce of aflatoxigenic Aspergillus growth is serious concern around the world especially prevalent in developing countries. There are different physical, chemical, and biological methods for reduction of Aspergillus growth in contaminated animal feeds, but only a few of these methods have been accepted for practical use (Kohl et al. 2011). One of mentioned methods is inhibition of Aspergillus spp. growth by lactic acid bacteria (LAB) (Sangmanee and Hongpattarakere 2014). The use of LAB as a natural biopreservative is highly regarded because of their GRAS (generally recognized as safe) status (Belguesmia et al. 2013). In several studies, oral safety of LAB strains has been confirmed. Accordingly, these microorganisms can be used as safe biosupplements in food and pharmaceutical applications (Lara-Villoslada et al. 2007; Tsai et al. 2014; Damodharan et al. 2015).
LAB are a group of microaerophilic bacteria, Gram-positive, non-respiring, non-spore forming, catalase-negative, cocci, or rod cells (Sangmanee and Hongpattarakere 2014). In recent years, various researchers have studied antifungal activity of LAB isolated from traditional fermented foods. In these studies, antifungal potential of Lactobacillus spp. (Sangmanee and Hongpattarakere 2014; Delavenne et al. 2015; Bian et al. 2016; Russo et al. 2016; Dong et al. 2017), Enterococcus spp. (Belguesmia et al. 2013), Lactococcus spp. (Roy et al. 1996; Varsha et al. 2016), and Pediococcus spp. (Dalie et al. 2010; Sadeghi et al. 2016; Sellamani et al. 2016) has also been described.
LAB isolates produce antifungal metabolites including 4-hydroxy-phenyllactic acid and phenyllactic acid (Lavermicocca et al. 2000), 3,6-bis(2-methylpropyl)-2,5-piperazinedion (Yang and Chang 2010), certain organic acids such as acetic acid, propionic acid, and lactic acid (Özcelik et al. 2016), hydroxy fatty acids (Sjogren et al. 2003), and cyclic dipeptides (Strom et al. 2002). These metabolites usually inhibit fungal spoilage by controlling the growth of toxigenic molds (Özcelik et al. 2016).
Due to the presence of LAB, traditional fermented products are usually less exposed to fungal spoilage. Therefore, microbial ecology of these products, especially non-aseptic fermented product ecosystems may be lead to identification of LAB isolates with unique antifungal capabilities. The objective of present study was to molecular identification and investigating the antifungal properties of native LAB isolated from traditional fermented products.
Material and methods
Indicator fungi
Aflatoxin producing A. flavus (PTCC 5004) and A. niger (PTCC 5154) were purchased from Iranian Research Organization for Science and Technology (IROST). These fungi were grown on yeast extract glucose chloramphenicol agar (YGC) (Merck, Germany) at 26 °C for 7 days. Fungal spores were harvested by addition of sterile Tween 80 solution (Merck, Germany) at 0.05% (v/v). Spore concentrations were adjusted to 104 spores/ml by a hemocytometer chamber (Wang et al. 2012).
Isolation and molecular identification of LAB
Ten different samples of traditional fermented products including Chal: fermented camel milk (four samples), whole barley sourdough (three samples), and whole wheat sourdough (three samples) were collected from rural area in north of Iran (Golestan Province). The samples were placed in a cooling box and transported to the Department of Food Science, Gorgan University of Agricultural Sciences and Natural Resources. Ten grams of each sample was stomachered in 90 ml of sterile ringer solution (Merck, Germany) with a Stomacher 400 (Seward, England) at 260 rpm for 3 min. An aliquot (1 ml) of the homogenate sample was spread plated onto MRS (de Man, Rogosa, and Sharpe) agar (Merck, Germany) and plates were then incubated at 37 °C in 10% CO2 for 48 h. After incubation, colonies were streaked on MRS agar plates for obtaining single colonies. Then colonies were tested for Gram-stain morphology, catalase activity, and microscopic cell morphology (Yang et al. 2012).
For molecular identification, isolated strains were cultured in MRS broth at 37 °C in 10% CO2 for 24 h, and DNA was extracted using the purification kit based on the manufacturer’s protocol (GeneAll, Korea). 16S rRNA gene of isolates were subjected to PCR amplification with primers F44 (5′-RGTTYGATYMTGGCTCAG-3′) and R1543 (5′-GNNTACCTTKTTACG ACTT-3′) by a thermo-cycler (Corbett N15128, Australia). Optimized PCR reaction was carried out according to Yang et al. (2012) in 20-μl final volume including 10-μl Taq DNA polymerase master mix red (Ampliqon, Denmark), 1.5 μl of each primer at concentration of 0.5 mM, 5 μl ddH2O, and 2 μl DNA with concentration of 100 ng/μl. Subsequently, PCR products (1500 bp amplicon) were electrophoresed in 1.5% (w/v) agarose gel in TBE buffer for 40 min at a constant voltage of 90 V and were visualized by UV transilluminator (Kiagen, Iran). Finally, the PCR products were sequenced by MWG Co. (Germany) and the sequencing results were checked by BLASTn procedure with available data in gene bank.
Antifungal activity of LAB isolates
Overlay method was used to investigate the antifungal activity of LAB isolates with slight modifications (Magnusson and Schnurer 2001). This method was performed using MRS agar plates (6 cm) on which LAB were inoculated as two 3-cm-long lines and incubated at 37 °C for 72 h in 10% CO2. The plates were then overlaid with 15 ml of YGC agar containing 104 fungal spores/ml and incubated at 26 °C until the fungi growth was almost complete in the control plates. Inhibition zones in the pictures taken by a digital camera were measured by the ImageJ software (version 1.41).
Determination of logarithmic and stationary phases of LAB isolate
Overnight culture of the most effective LAB isolate was diluted to 103 CFU/ml in MRS broth and then incubated at 37 °C in 10% CO2. Quantities of optical density (OD) of the isolate culture were monitored by spectrophotometer (LTD-T80T, England) at 600 nm at 1-h intervals, until receiving the growth curve to stationary phase (Gulahmadov et al. 2009).
Preparation of cell-free supernatants (CFSs) from LAB isolate
After twice activation of each LAB isolate in MRS broth, CFSs from logarithmic and stationary phases were respectively prepared from culture collected 2 h before and after the end of the logarithmic phase. The supernatant was then centrifuged (Sigma 2-16 KL, United States) at 4 °C, 14,000 g for 5 min and subsequently filtered through sterile 0.22-μm syringe microfilters (Biofil, China) to obtain the untreated CFS (Wang et al. 2012).
Antifungal activity of CFSs
Antifungal activity of CFSs was tested as reported by Wang et al. (2012) with some modifications. Briefly, CFSs were mixed with YGC (45 °C) to achieve a final concentration of 1–10%. Fungal spores (3 μl of Aspergillus spore suspensions containing 104 spore/ml) were then spotted at the center of plates and incubated at 26 °C. The control YGC plate was CFS-free and containing 10% (v/v) of sterile distilled water that was inoculated with 3 μl of Aspergillus spores at the center. Antifungal activity of CFS was measured by the ImageJ software, until the fungi growth in the control plates was almost complete. The lowest CFS concentration that inhibited visible growth of Aspergillus was also defined as minimum inhibitory concentration (MIC).
Preparation of activated Pediococus lolii for oral gavage in rats
For this purpose, the method of Tsai et al. (2014) was used. Briefly, bacteria grown in MRS broth were harvested by centrifugation (10,000 rpm for 5 min at 4 °C), then washed twice with phosphate-buffered saline (PBS), and resuspended in PBS to final OD of 0.8 (108 CFU cells/ml) at 600 nm, as measured by a spectrophotometer (LTD, England).
Safety assessment
Eighteen 4-week female Wistar rats were purchased from Pasteur Institute of Iran. Eighteen rats were then divided into two different groups for feeding and each rat was placed in a separate cage. For 28 days, the rats received orally/daily 100 μl of PBS containing 108 CFU of P. lolii, while control group received 100 μl PBS only. The rats were also given free access to food and drinking water and the housing conditions were 22 ± 3 °C with relative humidity of 60 ± 5% and a 12-h dark and 12-h light cycle. These animals were observed daily, and weight, behavior, activity, and hair luster were recorded. Specific growth rate (SGR) or average weekly weight gain (g) was calculated based on the following formula: (W − W 0 / W 0) × 100. W and W 0 indicate the rat weight on the defined feeding days and on day 0, respectively. On day 28, all rats were sacrificed and blood samples were collected for laboratory analysis. Platelet counts, red blood cell counts (RBC), white blood cells counts (WBC), mean corpuscular hemoglobin concentration (MCHC), mean corpuscular hemoglobin (MCH), and mean corpuscular volume (MCV) were determined by Kavosh Laboratory (Gorgan, Iran). Furthermore, plasma levels of liver enzymes including alanine transaminase (ALT), aspartate transaminase (AST), and alkaline phosphatase (ALP) were also determined (Tsai et al. 2014).
Statistical analysis
All experiments were performed in triplicate, and data were reported as mean ± standard error. LSD multiple comparison was also applied to obtain significance level (P < 0.05). All tests were analyzed using one-way analysis of variance (ANOVA) design with SPSS software (version 20).
Results
Molecular identification of LAB isolates
A total of 40 potential LAB strains were randomly isolated from fermented products on MRS agar; 28 of these isolates (12 isolates from Chal, nine isolates from whole wheat sourdough, and seven isolates from whole barley sourdough) were Gram positive, catalase negative, cocci or rod, and non-spore forming bacteria. Molecular identification of the isolates was done by specific PCR as described above. Fig. 1 shows the agarose gel electrophoresis of PCR products with a target gene of about 1500 bp. These 28 isolates were identified by sequencing of the 16S rRNA gene that showed 99% similarity with the corresponding species in the NCBI database (Table 1).
Antifungal activity of LAB isolates
Antifungal activity of LAB isolates is shown in Table 2 (against A. flavus) and in Table 3 (against A. niger). As it is indicated in Table 2, A. flavus filled the entire surface of the control plate at the end of the fourth day, while LAB isolates showed different inhibitory effects ranging from 0–53.68% (Chal), 4.26–65.9% (whole wheat sourdough), and 27.61–70.32% (whole barley sourdough). After 4 days, among the 28 isolates of tested LAB, eight isolates from Chal and three isolates from whole wheat sourdough had no inhibitory effect against A. flavus, while all isolated LAB from whole barley sourdough had significant effect on A. flavus growth (P < 0.05) in comparison to control plate.
Among the entire LAB isolates, P. lolii isolated from whole barley sourdough had the highest inhibitory effect (70.32% inhibition) against A. flavus (Fig. 2). In this study, we also observed that LAB isolated from traditional fermented products had proper inhibitory effect against A. niger growth. A. niger filled the entire surface of the control plate at the end of the fifth day, but growth of the mold in the presence of LAB isolated from Chal, whole wheat, and whole barley sourdoughs ranged from 28.49–95.06, 26.96–100, and 1.2–33.15% after 5 days, respectively (Table 3). According to our finding, LAB isolated from whole barley sourdough showed a broad spectrum of antifungal activity against A. niger and among the isolates, P. lolii (Fig. 2) and Pediococus pentaseous had respectively the highest inhibitory effects against A. niger growth with 98.8 and 74.21% inhibition at the end of the fifth day.
Antifungal activity of CFSs
Based on the results of overlay tests in the present study, P. lolii showed the highest antifungal activity against A. flavus and A. niger and so on. We focused on investigating the antifungal activity of P. lolii CFS. Stationary phase from P. lolii was started 10 h after incubation (data not shown). Therefore, CFSs from logarithmic and stationary phases were respectively prepared after 8 and 12 h after incubation. Table 4 shows the antifungal activity of CFSs obtained from P. lolii against A. flavus. According to Table 4 data, the MIC values of P. lolii CFSs from logarithmic and stationary phases against A. flavus were 2 and 1% (v/v), respectively. The media containing 9% of logarithmic phase CFS and 7% of stationary phase CFS completely inhibited the growth of A. flavus mycelia.
The results indicated that antifungal activity of P. lolii stationary phase CFS was significantly (P < 0.05) higher than the effect of the logarithmic phase CFS. In addition, the media containing ≥4% of the stationary phase CFS (v/v) had totally inhibited from germination of A. flavus spores (Fig. 3).
MIC values of P. lolii CFSs from logarithmic and stationary phases against A. niger were shown in Table 4, too. MIC value of the stationary phase CFS was 1%, while for the logarithmic phase was 4%. Complete inhibition from A. niger growth was also occurred at 8% of logarithmic phase CFS and 6% of stationary phase CFS, respectively. Fig. 4 indicates that germination of A. niger spores was absolutely inhibited in the presence of 4% or more of the stationary phase CFS (v/v).
SGR, hematological, and clinical chemistry parameters
SGR of rats is shown in Table 5. Based on these results, during 28-day oral administration of P. lolii, the SGR increased in both control and treated groups but there was no significant difference (P > 0.05) between control and treated groups on the defined feeding days. Furthermore, any noticeable difference in the activity, behavior, and hair luster of the rats was observed in comparison to control group.
Clinical chemistry and hematological analysis data were also shown in Table 6. As it is indicated, in treated group, no significant change was observed in platelets, WBC, RBC, MCH, MCHC, MCV, and liver enzymes and all values were within normal physiological ranges.
Discussion
Modern agriculture and animal production systems need to reliable and safe methods to prevent and minimize Aspergillus growth rate. Inhibition of the mold growth by natural biological antagonists is a good example of these safe and efficient ways (Sangmanee and Hongpattarakere 2014). Furthermore, consumer demand for reduced use of antibiotics and chemical preservatives has led to more interest in biological preservation of foods and animal feeds in recent years. Among natural preservatives, LAB are special interest groups and their application has a long history in foods and animal feeds (Russo et al. 2016; Khanafari et al. 2007). Fermented foods such as sourdough are the most common sources for LAB isolation. Based on competition ability and adaptability of predominant sourdough LAB to non-aseptic conditions of this fermented ecosystem, these LAB usually show strong antimicrobial activity (Sadeghi et al. 2016).
In the present study, we identified 28 LAB isolates by PCR method. Among those, 12 and nine LAB isolated from Chal and wheat sourdough belonged to the genera of Lactobacillus and Enterococcus, respectively. Moreover, seven LAB isolated from barely sourdough belonged to the genera of Lactobacillus and Pediococcus. Among mentioned isolates, P. lolii had the highest inhibitory effects against A. flavus and A. niger. According to these results, antifungal activity of P. lolii stationary phase CFS was higher than logarithmic phase CFS significantly (P < 0.05). Few studies have been conducted on P. lolii functional features. For example, Lee et al. (2012) analyzed the profile of organic acid in culture media of P. lolii by GC/MS and recently, Ju et al. (2016) confirmed the protective efficacy of P. lolii against influenza virus but there is no report about the antifungal activity of P. lolii until now. It should be noted that we identified P. lolii with strong antifungal activity from traditional whole barely sourdough for the first time.
Digaitiene et al. (2012) identified five strains of antifungal LAB (Lactobacillus sakei KTU05-06, Pediococcus acidilactici KTU05-7, Pediococcus pentosaceus KTU05-8, KTU05-9, and KTU05-10) with high activity against Aspergillus, Fusarium, Mucor, and Penicillium. Accordingly, antifungal LAB may be used as a suitable biopreservative to control the fungal spoilage in food and feed products. Antifungal activity of L. rhamnosus L60 and L. fermentum L23 was approved against aflatoxigenic Aspergillus spp. by Gerbaldo et al. (2012). Lactobacilli strains fully inhibited the Aspergillus growth of all strains assayed. Mentioned researchers have also concluded that mold contaminants of animal feeds could be significantly controlled by L60 and L23 strains. Rather et al. (2014) isolated Lactobacillus plantarum YML007 from Korean kimchi. L. plantarum YML007 and its supernatant delayed the growth of A. niger, A. flavus, Fusarium oxysporum, Saccharomyces cerevisiae, Candida albicans, and Pichia membranifaciens in maize. Furthermore, Wistar rats fed with supernatant treated maize showed more weight gain, compared with the control group. Based on these studies, antifungal activity of LAB is due to synergistic interactions between their metabolites such as weak organic acids, free fatty acids, cyclic dipeptides, piperidine derivatives, phenyl lactic acid, and phenolic compounds. Furthermore, recently, antifungal activity of cyclic dipeptides (Muhialdin et al. 2016), organic acids (Özcelik et al. 2016; Russo et al. 2016), and phenyl lactic acid (Russo et al. 2016) produced by LAB was approved. According to Strom et al. (2002), cyclic dipeptides are effective on quorum-sensing mechanism. Production of fungistatic bacteriocin-like substance by regulating signal peptides in LAB is a type of this quorum sensing. Free fatty acids, organic acids, and phenyl lactic acid also directly interact with the lipid bi-layer of fungi cell membrane and increase its fluidity. This interaction leads to change in membrane proteins, release of intracellular materials, cytoplasmic disorder, and finally cell destruction (Avis and Belanger 2001).
Some LAB strains produce piperidine derivatives (Li et al. 2012) and phenolic compounds (Annan et al. 2003) by several antifungal activities. Piperidine derivatives inhibit α-glycosidase activity, which plays a crucial role in gene regulation corresponding to carbohydrate metabolism in Aspergillus (Kato et al. 2002). Phenolic compounds can also interact with free radicals and prevent from formation of hydroperoxy molecules (Annan et al. 2003), which are essential for both sexual and asexual body development of filamentous Aspergillus spp. (Calvo et al. 2001).
In the present study, we also observed that oral administration of P. lolii led to significant increase in the SGR of rats. Moreover, hematological and clinical chemistry parameters of the rats did not differ significantly from those of the control group. Over the past years, various researchers have reported safety of LAB isolated from traditional fermented foods. In these studies, safety of Pediococcus spp. (Tsai et al. 2014), Lactobacillus spp. (Sulemankhil et al. 2012; Jones et al. 2012; Szabo et al. 2011), and Enterococcus spp. (Tsai et al. 2004) has also been described. They reported that LAB isolates had no adverse effects regarding the behavior, activity, hematology, clinical chemistry indices, and growth rate of rats in comparison to control group.
Conclusion
In conclusion and based on our results, by considering the proper antifungal activity of P. lolii isolate and its CFS against aflatoxigenic Aspergillus spp. and approval of the isolate safety, it is possible to use from mentioned LAB and its CFS as biopreservative agents in processing of different foods and feeds.
References
Annan NT, Poll L, Sefa-Dedeh S, Plahar WA, Jakobsen M (2003) Volatile compounds produced by Lactobacillus fermentum, Saccharomyces cerevisiae and Candida krusei in single starter culture fermentations of Ghanaian maize dough. J Appl Microbiol 94:462–474
Avis TJ, Belanger RR (2001) Specificity and mode of action of the antifungal fatty acid cis-9-heptadecenoic acid produced by Pseudozyma flocculosa. Appl Environ Microb 67:956–960
Belguesmia Y, Choiset Y, Rabesona H, Baudy-Floc'h M, Le Blay G, Haertle T, Chobert JM (2013) Antifungal properties of durancins isolated from Enterococcus durans A5-11 and of its synthetic fragments. Lett Appl Microbiol 56:237–244
Bian X, Muhammad Z, Evivie SE, Luo WXM, Huo GC (2016) Screening of antifungal potentials of Lactobacillus helveticus KLDS 1.8701 against spoilage microorganism and their effects on physicochemical properties and shelf life of fermented soybean milk during preservation. Food Control 66:183–189
Calvo AM, Gardner HW, Keller NP (2001) Genetic connection between fatty acid metabolism and sporulation in Aspergillus nidulans. J Biol Chem 276:25766–25774
Dalie DKD, Deschamps AM, Atanasova-Penichon V, Richard-Forget F (2010) Potential of Pediococcus pentosaceus (L006) isolated from maize leaf to suppress fumonisin-producing fungal growth. J Food Protect 73:1129–1137
Damodharan K, Lee YS, Palaniyandi SA, Yang SH, Suh JW (2015) Preliminary probiotic and technological characterization of Pediococcus pentosaceus strain KID7 and in vivo assessment of its cholesterol-lowering activity. Front Microbiol 6. doi:10.3389/fmicb.2015.00768
Delavenne E, Cliquet S, Trunet C, Barbier G, Mounier J, Blay GL (2015) Characterization of the antifungal activity of Lactobacillus harbinensis K.V9.3.1Np and Lactobaciilus rhamnosus K.C8.3.11 in yogurt. Food Microbiol 45:10–17
Digaitiene A, Hansen AS, Juodeikiene G, Eidukonyte D, Josephsen J (2012) Lactic acid bacteria isolated from rye sourdoughs produce bacteriocin-like inhibitory substances active against Bacillus subtilis and fungi. J Appl Microbiol 112:732–742
Dong AR, Ho TT, Lo R, Bansal N, Turner MS (2017) A genetic diversity study of antifungal Lactobacillus plantarum isolates. Food Control 72:83–89
Gerbaldo GA, Barberis C, Pascual L, Dalcero A, Barberis L (2012) Antifungal activity of two Lactobacillus strains with potential probiotic properties. FEMS Microbiol Lett 332:27–33
Gulahmadov SG, Abdullaeva NF, Guseinova NF, Kuliev AA, Ivanova IV, Dalgalarondo M, Chobert JM, Haertlee T (2009) Isolation and characterization of bacteriocin-like inhibitory substances from lactic acid bacteria isolated from Azerbaijan cheeses. Appl Biochem Microbiol 45:266–271
Jones ML, Martoni CJ, Tamber S, Parent M, Prakash S (2012) Evaluation of safety and tolerance of microencapsulated Lactobacillus reuteri NCIMB 30242 in a yogurt formulation: a randomized, placebo-controlled, double-blind study. Food Chem Toxicol 50:2216–2223
Ju H, Youn H, Kwon J, Hong W, Song C (2016) Protective efficacy of Pediococcus lolii against Influenza a virus. Conference proceeding. Paper presented at International Scientific Conference on Probiotics and Prebiotics 2016, Budapest. In Kysucke Nove Mesto, by PAMIDA International. ISBN-978-80-89589-14-2
Kabak B, Brandon EFA, Var I, Blokland M, Sips AJAM (2009) Effects of probiotic bacteria on the bioaccessibility of aflatoxin B1 and ochratoxin A using an in vitro digestion model under fed conditions. Journal of Environmental Science and Health 44:472–480
Kato N, Suyama S, Shirokane M, Kato M, Kobayashi T, Tsukagoshi T (2002) Novel α-glucosidase from Aspergillus nidulans with strong transglycosylation activity. Appl Environ Microb 68:1250–1256
Khanafari A, Soudi H, Miraboulfathi M (2007) Biocontrol of Aspergillus flavus and aflatoxin B1 production corn. Iran J Environ Health Sci Eng 4:163–168
Kohl J, Postma J, Nicot P, Ruocco M, Blum B (2011) Stepwise screening of microorganisms for commercial use in biological control of plant-pathogenic fungi and bacteria. Biol Control 57:1–12
Lara-Villoslada F, Sierra S, Martín R, Delgado S, Rodríguez JM, Olivares M, Xaus J (2007) Safety assessment of two probiotic strains, Lactobacillus coryniformis CECT5711 and Lactobacillus gasseri CECT5714. J Appl Microbiol 103:175–184
Lavermicocca P, Valerio F, Evidente A, Lazzaroni S, Corsetti A, Gobbetti M (2000) Purification and characterization of novel antifungal compounds from the sourdough Lactobacillus plantarum strain 21B. Appl Environ Microb 66:4084–4090
Lee JY, Nguyenb DT, Parka YS, Hwanga KY, Choa YS, Kanga KD, Yoonb J, Yuc J, Yeed SD, Ahne YH, Leeb G, Seonga SL, Paikd MJ (2012) Organic acid profiling analysis in culture media of lactic acid bacteria by gas chromatography-mass spectrometry. Mass Spectrom Lett 3:74–77
Li H, Liu L, Zhang S, Cui W, Lv J (2012) Identification of antifungal compounds produced by Lactobacillus casei AST18. Curr Microbiol 65:156–161
Magnusson J, Schnurer J (2001) Lactobacillus coryniformis subsp. coryniformis strain Si3 produces a broad-spectrum proteinaceous antifungal. Appl Environ Microb 67:1–5
Muhialdin BJ, Hassan Z, Bakar FA, Saari N (2016) Identification of antifungal peptides produced by Lactobacillus plantarum IS10 grown in the MRS broth. Food Control 59:27–30
Özcelik S, Kuley E, Özogul F (2016) Formation of lactic, acetic, succinic, propionic, formic and butyric acid by lactic acid bacteria. LWT - Food Sci Technol 73:536–542
Quiles JM, Saladino F, Manes J, Fernandez-Franzon M, Meca G (2016) Occurrence of mycotoxins in refrigerated pizza dough and risk assessment of exposure for the Spanish population. Food Chem Toxicol 94:19–24
Rather IA, Seo BJ, Kumar VJR, Choi UH, Choi KH, Lim J, Park YH (2014) Biopreservative potential of Lactobacillus plantarum YML007 and efficacy as a replacement for chemical preservatives in animal feed. Food Sci Biotechnol 23:195–200
Roy U, Batish VK, Grover S, Neelakantan S (1996) Production of antifungal substance by Lactococcus lactis subsp. lactis CHD-28.3. Int J Food Microbiol 32:27–34
Russo P, Arena MP, Fiocco D, Capozzi V, Drider D, Spano G (2016) Lactobacillus plantarum with broad antifungal activity: a promising approach to increase safety and shelf-life of cereal-based products. Int J Food Microbiol In Press, Corrected Proof
Sadeghi A, Raeisi M, Ebrahimi M, Sadeghi B (2016) Antifungal activity of Pediococcus pentosaceus isolated from whole barley sourdough. J Food Qual Hazards Control 3:30–36
Sangmanee P, Hongpattarakere T (2014) Inhibitory of multiple antifungal components produced by Lactobacillus plantarum K35 on growth, aflatoxin production and ultrastructure alterations of Aspergillus flavus and Aspergillus parasiticus. Food Control 40:224–233
Sellamani M, Kalagatur NK, Siddaiah C, Mudili V, Krishna K, Natarajan G, Rao Putcha VL (2016) Antifungal and zearalenone inhibitory activity of Pediococcus pentosaceus isolated from dairy products on Fusarium graminearum. Front Microbiol 7: doi: 10.3389/fmicb.2016.00890
Sjogren J, Magnusson J, Broberg A, Schnürer J, Kenne L (2003) Antifungal 3-hydroxy fatty acids from Lactobacillus plantarum MiLAB 14. Appl Environ Microb 69:7554–7557
Strom K, Sjogren J, Broberg A, Schnurer J (2002) Lactobacillus plantarum MiLAB 393 produces the antifungal cyclic dipeptides cyclo(L-Phe-L-Pro) and cyclo(L-Phe-trans-4-OH-L-Pro) and 3-phenyllactic acid. Appl Environ microb 68:4322–4327
Sulemankhil I, Parent M, Jones ML, Feng Z, Labbe A, Prakash S (2012) In vitro and in vivo characterization and strain safety of Lactobacillus reuteri NCIMB 30253 for probiotic applications. Can J Microbiol 58:776–787
Szabo NJ, DolanLC BGA, Shibano T, Sato S, Suzuki H, Uesugi T, Yamahira S, Toba M, Ueno H (2011) Safety evaluation of Lactobacillus pentosus strain b240. Food Chem Toxicol 49:251–258
Tsai CC, Liu TH, Chen MH, Tsen HY (2004) Toxicity evaluation for an Enterococcus faecium strain TM39 in vitro and in vivo. Food Chem Toxicol 42:1601–1609
Tsai CC, Leu SF, Huang QR, Chou LC, Huang CC (2014) Safety evaluation of multiple strains of Lactobacillus plantarum and Pediococcus pentosaceus in Wistar rats based on the Ames test and a 28-day feeding study. Scientific World J 2014: Article ID 928652, doi:10.1155/2014/928652
Varsha KK, Nishant G, Sneha SM, Shilpa G, Devendra L, Priya S, Nampoothiri KM (2016) Antifungal, anticancer and aminopeptidase inhibitory potential of a Phenazine compound produced by Lactococcus BSN307. Indian J Microbiol 56:411–416
Wang H, Yan Y, Wang J, Zhang H, Qi W (2012) Production and characterization of antifungal compounds produced by Lactobacillus plantarum IMAU10014. PLoS One 7:e29452
Yang EJ, Chang HC (2010) Purification of a new antifungal compound produced by Lactobacillus plantarum AF1 isolated from kimchi. Int J Food Microbiol 139:56–63
Yang E, Fan L, Yueming J, Doucette C, Fillmore S (2012) Antimicrobial activity of bacteriocin-producing lactic acid bacteria isolated from cheeses and yogurts. AMB Express 2:48–60
Author information
Authors and Affiliations
Corresponding author
Ethics declarations
Conflict of interest
The authors declare that they have no conflicts of interest.
Funding
This work is part of a PhD thesis supported by Gorgan University of Agricultural Sciences and Natural Resources and the authors thank the financial support.
Ethical approval
All applicable international, national, and/or institutional guidelines for the care and use of animals were followed.
Rights and permissions
About this article
Cite this article
Ebrahimi, M., Khomeiri, M., Masoudi-Nejad, A. et al. Inhibitory effects of lactic acid bacteria isolated from traditional fermented foods against aflatoxigenic Aspergillus spp.. Comp Clin Pathol 26, 1083–1092 (2017). https://doi.org/10.1007/s00580-017-2489-0
Received:
Accepted:
Published:
Issue Date:
DOI: https://doi.org/10.1007/s00580-017-2489-0